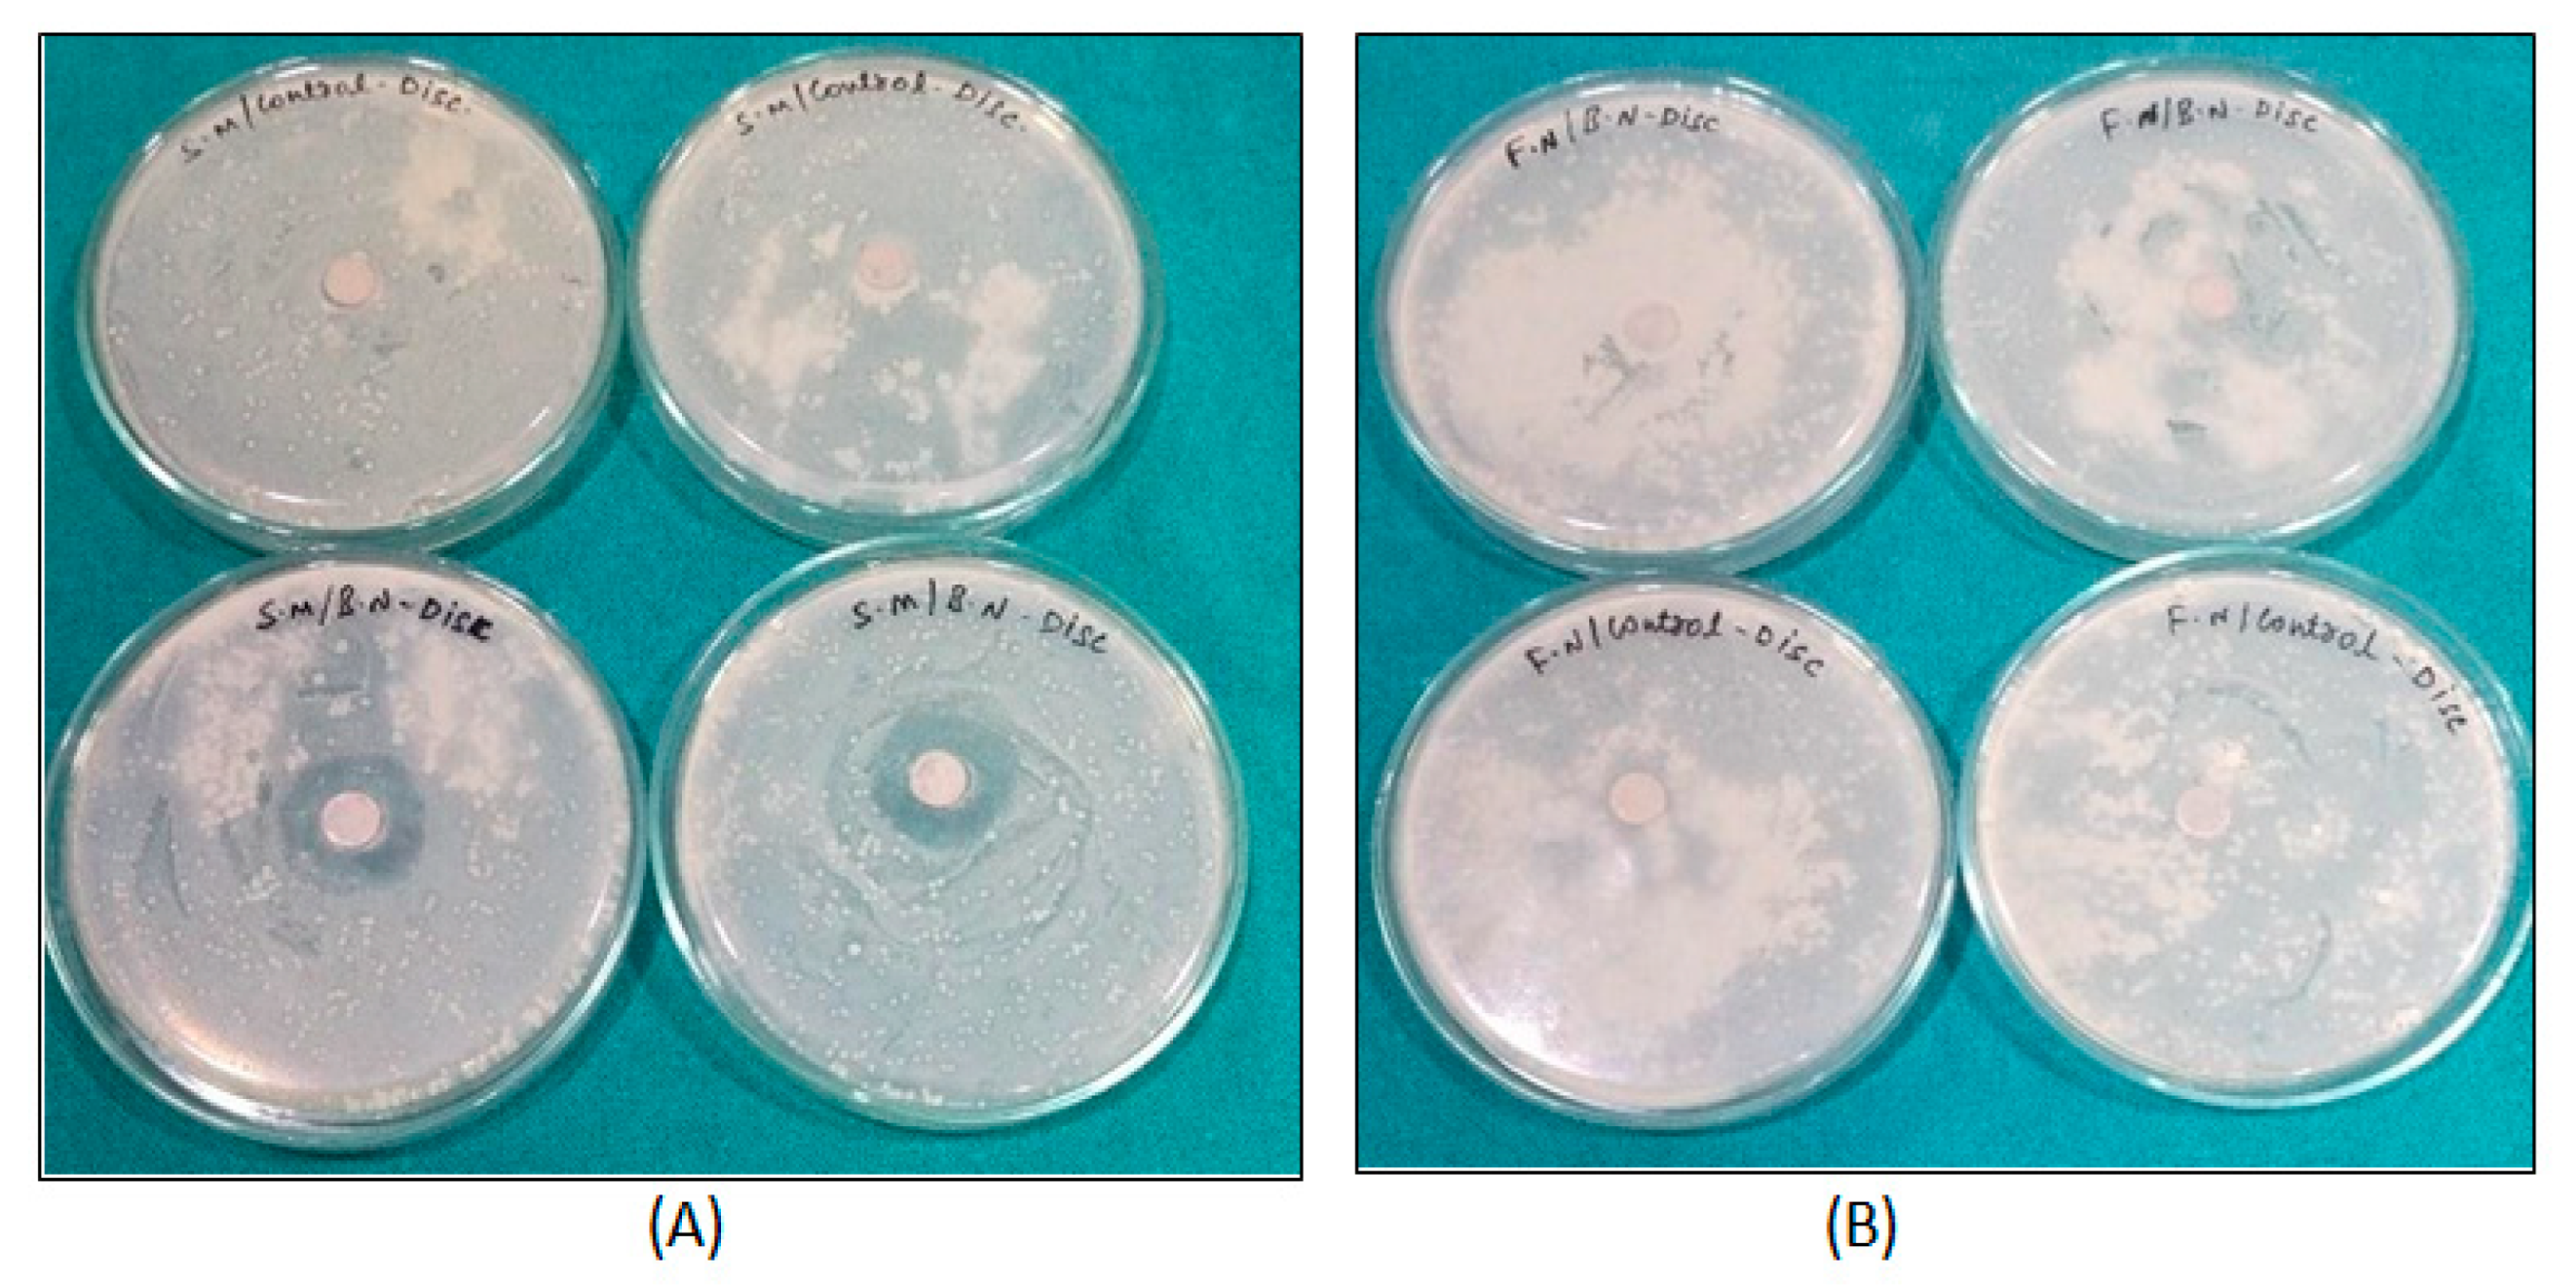

Antibacterial Efficacy and Surface Characteristics of Boron Nitride Coated Dental Implant: An In-Vitro Study
Abstract
1. Introduction
2. Materials and Methods
2.1. Preparation of Bn Solution
2.2. Coating Procedure
2.3. Surface Characterization
2.4. Bacterial Strains
- Incubation:
- Specimens were divided into these two groups:
- Group I: BN-coated titanium discs [BN],
- Group II: Uncoated titanium discs [Control].
2.5. Zone of Inhibition Test
2.6. Biofilm Adhesion Assay
2.7. SEM Analysis
2.8. Statistical Analysis
3. Results
3.1. Surface Characterization
3.2. Zone of Inhibition Test
3.3. Microbial Colony Forming Units (CFUs) Assay and Crystal Violet Staining Assay
3.4. SEM Analysis Results
3.5. EDS Analysis Results:
4. Discussion
5. Conclusions
- (1)
- Thin and uniform hydrophilic BN coating of 13–14 μm was achieved. In surface characterization, boron nitride showed good adhesion properties on the surface of titanium alloy discs.
- (2)
- Zone of inhibition tests done for S. mutans and F. nucleatum with control and BN-coated discs showed 11–13 mm in all BN-coated discs for S. mutans.
- (3)
- In microbial colony forming units (CFUs) assays, the CFUs of S. mutans and F. nucleatum were significantly greater in uncoated TI discs as compared to BN-coated discs.
- (4)
- In crystal violet assays, the growth phase of S. mutans bacteria was considerably less compared to F. nucleatum in coated discs. The optical density of BN-coated discs was less in S. mutans.
- (5)
- In SEM analysis, uncoated discs showed a mat layer of biofilm on the surface of the disc. Coated discs showed the characteristic nanospike-like structures of BN formed on the surface of the coating. This characteristic feature is responsible for bacterial cell wall damage.
- (5)
- EDS results showed a prominent release of boron and nitride elements. 1.1% by weight in B and 2.4% by weight in N elements were released from BN-coated discs with treatment. Without treatment, BN-coated discs released 1.2% by weight in B and 2.6 % by weight in N elements.
Author Contributions
Funding
Data Availability Statement
Acknowledgments
Conflicts of Interest
References
- Grobner-Schreiber, B.; Griepentrog, M.; Haustein, I.; Müller, W.D.; Briedigkeit, H.; Gobel, U.B.; Lange, K.P. Plaque formation on surface modified dental implants: An in vitro study. Clin. Oral Implants Res. 2001, 12, 543–551. [Google Scholar] [CrossRef] [PubMed]
- Gokmenogluce, C.; Ozmeric, N.; Çakal, G.; Dokmetas, N.; Ergene, C.; Kaftanoğlu, B. Coating of titanium implants with boron nitride by RF-magnetron sputtering. Bull. Mater. Sci. 2016, 39, 1363–1370. [Google Scholar] [CrossRef]
- Pandit, S.; Gaska, K.; Mokkapati, V.R.S.S.; Forsberg, S.; Svensson, M.; Kádár, R.; Mijakovic, I. Antibacterial effect of boron nitride flakes with controlled orientation in polymer composites. RSC Adv. 2019, 9, 33454–33459. [Google Scholar] [CrossRef] [PubMed]
- Nithya, J.S.M.; Pandurangan, A. Aqueous dispersion of polymer coated boron nitride nanotubes and their antibacterial and cytotoxicity studies. RSC Adv. 2014, 4, 32031–32046. [Google Scholar] [CrossRef]
- Nasr, M.; Soussan, L.; Viter, R.; Eid, C.; Habchi, R.; Miele, P.; Bechelany, M. High photodegradation and antibacterial activity of BN–Ag/TiO2 composite nanofibers under visible light. New J. Chem. 2018, 42, 1250–1259. [Google Scholar] [CrossRef]
- Gudz, K.; Permyakova, E.S.; Matveev, A.T.; Bondarev, A.V.; Manakhov, A.M.; Sidorenko, D.A.; Filippovich, S.Y.; Brouchkov, A.V.; Golberg, D.V.; Ignatov, S.G.; et al. Pristine and Antibiotic-Loaded Nanosheets/Nanoneedles-Based Boron Nitride Films as a Promising Platform to Suppress Bacterial and Fungal Infections. ACS Appl. Mater. Interfaces 2020, 12, 42485–42498. [Google Scholar] [CrossRef]
- Hu, W.; Peng, C.; Luo, W.; Lv, M.; Li, X.; Li, D.; Huang, Q.; Fan, C. Graphene-Based Antibacterial Paper. ACS Nano 2010, 4, 4317–4323. [Google Scholar] [CrossRef]
- Zou, X.; Zhang, L.; Wang, Z.; Luo, Y. Mechanisms of the antimicrobial activities of graphene materials. J. Am. Chem. Soc. 2016, 138, 2064–2077. [Google Scholar] [CrossRef] [PubMed]
- Wang, J.; Ma, F.; Sun, M. Graphene, hexagonal boron nitride, and their heterostructures: Properties and applications. RSC Adv. 2017, 7, 16801–16822. [Google Scholar] [CrossRef]
- Golberg, D.; Bando, Y.; Huang, Y.; Terao, T.; Mitome, M.; Tang, C.; Zhi, C. Boron Nitride Nanotubes and Nanosheets. ACS Nano 2010, 4, 2979–2993. [Google Scholar] [CrossRef] [PubMed]
- Kulunk, Ş.; Kulunk, T.; Ural, Ҫ.; Kurt, M.; Baba, S. Effect of air abrasion particles on the bond strength of adhesive resin cement to zirconia core. Acta Odontol. Scand. 2011, 69, 88–94. [Google Scholar] [CrossRef] [PubMed]
- Degrazia, F.W.; Leitune, V.C.B.; Samuel, S.M.W.; Collares, F.M. Boron nitride nanotubes as novel fillers for improving the properties of dental adhesives. J. Dent. 2017, 62, 85–90. [Google Scholar] [CrossRef]
- Lee, B.; Kwon, J.-S.; Khalid, M.W.; Kim, K.-M.; Kim, J.; Lim, K.M.; Hong, S.H. Boron nitride nanoplatelets as reinforcement material for dental ceramics. Dent. Mater. 2020, 36, 744–754. [Google Scholar] [CrossRef] [PubMed]
- Zafar, M.S. Prosthodontic applications of polymethyl methacrylate (PMMA): An update. Polymers 2020, 12, 2299. [Google Scholar] [CrossRef] [PubMed]
- Ciofani, G.; Raffa, V.; Menciassi, A.; Cuschieri, A. Cytocompatibility, interactions, and uptake of polyethyleneimine-coated boron nitride nanotubes by living cells: Confirmation of their potential for biomedical applications. Biotechnol. Bioeng. 2008, 101, 850–858. [Google Scholar] [CrossRef]
- Chen, X.; Wu, P.; Rousseas, M.; Okawa, D.; Gartner, Z.; Zettl, A.; Bertozzi, C.R. Boron Nitride Nanotubes Are Noncytotoxic and Can Be Functionalized for Interaction with Proteins and Cells. J. Am. Chem. Soc. 2009, 131, 890–891. [Google Scholar] [CrossRef]
- Lahiri, D.; Rouzaud, F.; Richard, T.; Keshri, A.K.; Bakshi, S.R.; Kos, L.; Agarwal, A. Boron nitride nanotube reinforced polylactide–polycaprolactone copolymer composite: Mechanical properties and cytocompatibility with osteoblasts and macrophages in vitro. Acta Biomater. 2010, 6, 3524–3533. [Google Scholar] [CrossRef]
- Ciofani, G.; Raffa, V.; Yu, J.; Chen, Y.; Obata, Y.; Takeoka, S.; Menciassi, A.; Cuschieri, A. Boron Nitride Nanotubes: A Novel Vector for Targeted Magnetic Drug Delivery. Curr. Nanosci. 2009, 5, 33–38. [Google Scholar] [CrossRef]
- Yang, C.-K. Exploring the interaction between the boron nitride nanotube and biological molecules. Comput. Phys. Commun. 2011, 182, 39–42. [Google Scholar] [CrossRef]
- Li, L.; Li, L.H.; Ramakrishnan, S.; Dai, X.J.; Nicholas, K.; Chen, Y.; Chen, Z.; Liu, X. Controlling Wettability of Boron Nitride Nanotube Films and Improved Cell Proliferation. J. Phys. Chem. C 2012, 116, 18334–18339. [Google Scholar] [CrossRef]
- Li, L.H.; Chen, Y.; Glushenkov, A.M. Boron nitride nanotube films grown from boron ink painting. J. Mater. Chem. 2010, 20, 9679–9683. [Google Scholar] [CrossRef]
- Walton, T.R. An Up-to-15-Year Comparison of the Survival and Complication Burden of Three-Unit Tooth-Supported Fixed Dental Prostheses and Implant-Supported Single Crowns. Int. J. Oral Maxillofac. Implant. 2015, 30, 851–861. [Google Scholar] [CrossRef]
- Tyona, M.D. A the oretical study on spin coating technique. Adv. Mater Res. 2013, 2, 195. [Google Scholar] [CrossRef]
- Feoktistova, M.; Geserick, P.; Leverkus, M. Crystal Violet Assay for Determining Viability of Cultured Cells. Cold Spring Harb. Protoc. 2016, 2016, 087379. [Google Scholar] [CrossRef] [PubMed]
- Shuai, C.; Feng, P.; Wu, P.; Liu, Y.; Liu, X.; Lai, D.; Gao, C.; Peng, S. A combined nanostructure constructed by graphene and boron nitride nanotubes reinforces ceramic scaffolds. Chem. Eng. J. 2017, 313, 487–497. [Google Scholar] [CrossRef]
- Madi, M.; Alagl, A.S. The Effect of Different Implant Surfaces and Photodynamic Therapy on Periodontopathic Bacteria Using TaqMan PCR Assay following Peri-Implantitis Treatment in Dog Model. BioMed. Res. Int. 2018, 2018, 75701–75707. [Google Scholar] [CrossRef]
- Vilarrasa, J.; Delgado, L.M.; Galofré, M.; Àlvarez, G.; Violant, D.; Manero, J.M.; Blanc, V.; Gil, F.J.; Nart, J. In vitro evaluation of a multispecies oral biofilm over antibacterial coated titanium surfaces. J. Mater. Sci. Mater. Med. 2018, 29, 164. [Google Scholar] [CrossRef]
- Choi, S.-H.; Jang, Y.-S.; Jang, J.-H.; Bae, T.-S.; Lee, S.-J.; Lee, M.-H. Enhanced antibacterial activity of titanium by surface modification with polydopamine and silver for dental implant application. J. Appl. Biomater. Funct. Mater. 2019, 17, 272–279. [Google Scholar] [CrossRef]
- Bose, S.; Surendhiran, D.; Chun, B.-S.; Arthanari, S.; Tran, V.N.; Lee, H.; Kang, H.W. Facile synthesis of black phosphorus-zinc oxide nanohybrids for antibacterial coating of titanium surface. Colloids Surfaces B Biointerfaces 2022, 219, 112807. [Google Scholar] [CrossRef] [PubMed]
- Alqahtani, M. Mechanical properties enhancement of self-cured PMMA reinforced with zirconia and boron nitride nanopowders for high-performance dental materials. J. Mech. Behav. Biomed. Mater. 2020, 110, 103937. [Google Scholar] [CrossRef]
- Sahrmann, P.; Gilli, F.; Wiedemeier, D.B.; Attin, T.; Schmidlin, P.R.; Karygianni, L. The Microbiome of Peri-Implantitis: A Systematic Review and Meta-Analysis. Microorganisms 2020, 8, 661. [Google Scholar] [CrossRef]
- Iușan, S.A.L.; Lucaciu, O.P.; Petrescu, N.B.; Mirică, I.C.; Toc, D.-A.; Albu, S.; Costache, C. The Main Bacterial Communities Identified in the Sites Affected by Periimplantitis: A Systematic Review. Microorganisms 2022, 10, 1232. [Google Scholar] [CrossRef]
- Girão, A.V.; Caputo, G.; Ferro, M.C. Application of Scanning Electron Microscopy–Energy Dispersive X-ray Spectroscopy (SEM-EDS). Compr. Anal. Chem. 2017, 75, 153–168. [Google Scholar] [CrossRef]
- Hamada, Y.; Shin, D.; John, V. Peri-Implant Disease—A Significant Complication of Dental Implant Supported Restorative Treatment. J. Indiana Dent. Assoc. 2016, 95, 31–38. [Google Scholar]
- Krishnamoorthy, K.; Veerapandian, M.; Zhang, L.H.; Yun, K.; Kim, S.J. Antibacterial efficiency of graphene nanosheets against pathogenic bacteria via lipid peroxidation. J. Phys. Chem. C 2012, 116, 17280–17287. [Google Scholar] [CrossRef]
- Tonetti, M.S.; Chapple, I.L.; Jepsen, S.; Sanz, M. Primary and secondary prevention of periodontal and peri-implant diseases: Introduction to, and objectives of the 11th European Workshop on Periodontology consensus conference. J. Clin. Periodontol. 2015, 42, S1–S4. [Google Scholar] [CrossRef] [PubMed]
- Chouirfa, H.; Bouloussa, H.; Migonney, V.; Falentin-Daudré, C. Review of titanium surface modification techniques and coatings for antibacterial applications. Acta Biomater. 2019, 83, 37–54. [Google Scholar] [CrossRef]
- Cheng, Y.; Mei, S.; Kong, X.; Liu, X.; Gao, B.; Chen, B.; Wu, J. Long-term antibacterial activity of a composite coating on titanium for dental implant application. J. Biomater. Appl. 2021, 35, 643–654. [Google Scholar] [CrossRef] [PubMed]
- Zhao, C.; Pandit, S.; Fu, Y.; Mijakovic, I.; Jesorka, A.; Liu, J. Graphene oxide based coatings on nitinol for biomedical implant applications: Effectively promote mammalian cell growth but kill bacteria. RSC Adv. 2016, 6, 38124–38134. [Google Scholar] [CrossRef]
- Wang, N.; Pandit, S.; Ye, L.; Edwards, M.; Mokkapati, V.; Murugesan, M.; Kuzmenko, V.; Zhao, C.; Westerlund, F.; Mijakovic, I.; et al. Efficient surface modification of carbon nanotubes for fabricating high performance CNT based hybrid nanostructures. Carbon 2017, 111, 402–410. [Google Scholar] [CrossRef]

| Microorganism | Disc Type | Zone of Inhibition (mm) | Z Value | p Value ª | ||
|---|---|---|---|---|---|---|
| Median | Interquartile Range | |||||
| S. mutans | Group I | 11.0 | 11.0–12.0 | 4.108 | 0.001 * | |
| Group II | 0.0 | 0.0–0.0 | ||||
| F. nucleatum | Group I | 0.0 | 0.0–0.0 | - | - | |
| Group II | 0.0 | 0.0–0.0 | ||||
| Group | Colony Forming Unit | Z Value | p Value ª | ||||
|---|---|---|---|---|---|---|---|
| Median | Inter-Quartile Range | ||||||
| S. mutans | Group I | 4.0 × 103 | 3.0 × 103–7.25 × 103 | 3.808 | 0.001 * | ||
| Group II | 843 × 106 | 669.5 × 106–964.25 × 106 | |||||
| F. nucleatum | Group I | 540.0 × 103 | 451.0 × 103–558.25 × 103 | −3.784 | 0.001 * | ||
| Group II | 555.5 × 106 | 534.0 × 106–566.25 × 106 | |||||
| S. mutans | Group | Optical Density | Z Value | p Value ª | |
|---|---|---|---|---|---|
| Median | Interquartile Range | ||||
| Optical density at 660 nm at 660 nm | Group I | 0.2725 | 0.2558–0.2898 | −3.784 | 0.001 * |
| Group II | 1.8540 | 1.7290–1.9758 | |||
| Optical density at 530 nm at 530 nm | Group I | 0.0870 | 0.0828–0.0890 | −3.787 −3.787 | 0.001 * |
| Group II | 0.6225 | 0.5715–0.7090 | |||
| F. nucleatum | Group | Optical Density | Z Value | p Value ª | |
| Median | Interquartile Range | ||||
| Optical density at 660 nm | Group I | 1.7230 | 1.6280–1.7990 | −0.835 | 0.436 |
| Group II | 1.6970 | 1.6250–1.7260 | |||
| Optical density at 530 nm | Group I | 1.0670 | 1.0195–1.0908 | −1.817 | 0.075 |
| Group II | 1.0905 | 1.0698–1.1280 | |||
| Elements with Treatment | Weight % | Atomic % | Error % |
|---|---|---|---|
| C K | 49.8 | 78.2 | 11.7 |
| O K | 15.9 | 21.2 | 12.9 |
| N K | 2.4 | 0.35 | 29.1 |
| Ti K | 30.8 | 1.6 | 7.5 |
| B K | 1.1 | 0.9 | 23.3 |
| Without Treatment | Weight % | Atomic % | Error % |
| C K | 50.4 | 77.2 | 10.2 |
| O K | 15.6 | 21.6 | 12.8 |
| N K | 2.6 | 0.4 | 27.8 |
| Ti K | 30.2 | 1.2 | 7.5 |
| B K | 1.2 | 0.9 | 24.3 |
Disclaimer/Publisher’s Note: The statements, opinions and data contained in all publications are solely those of the individual author(s) and contributor(s) and not of MDPI and/or the editor(s). MDPI and/or the editor(s) disclaim responsibility for any injury to people or property resulting from any ideas, methods, instructions or products referred to in the content. |
© 2023 by the authors. Licensee MDPI, Basel, Switzerland. This article is an open access article distributed under the terms and conditions of the Creative Commons Attribution (CC BY) license (https://creativecommons.org/licenses/by/4.0/).
Share and Cite
Raval, A.; S. Yadav, N.; Narwani, S.; Somkuwar, K.; Verma, V.; Almubarak, H.; Alqahtani, S.M.; Tasleem, R.; Luke, A.M.; Kuriadom, S.T.; et al. Antibacterial Efficacy and Surface Characteristics of Boron Nitride Coated Dental Implant: An In-Vitro Study. J. Funct. Biomater. 2023, 14, 201. https://doi.org/10.3390/jfb14040201
Raval A, S. Yadav N, Narwani S, Somkuwar K, Verma V, Almubarak H, Alqahtani SM, Tasleem R, Luke AM, Kuriadom ST, et al. Antibacterial Efficacy and Surface Characteristics of Boron Nitride Coated Dental Implant: An In-Vitro Study. Journal of Functional Biomaterials. 2023; 14(4):201. https://doi.org/10.3390/jfb14040201
Chicago/Turabian StyleRaval, Anjali, Naveen S. Yadav, Shweta Narwani, Kirti Somkuwar, Varsha Verma, Hussain Almubarak, Saeed M. Alqahtani, Robina Tasleem, Alexander Maniangat Luke, Sam Thomas Kuriadom, and et al. 2023. "Antibacterial Efficacy and Surface Characteristics of Boron Nitride Coated Dental Implant: An In-Vitro Study" Journal of Functional Biomaterials 14, no. 4: 201. https://doi.org/10.3390/jfb14040201
APA StyleRaval, A., S. Yadav, N., Narwani, S., Somkuwar, K., Verma, V., Almubarak, H., Alqahtani, S. M., Tasleem, R., Luke, A. M., Kuriadom, S. T., & Karobari, M. I. (2023). Antibacterial Efficacy and Surface Characteristics of Boron Nitride Coated Dental Implant: An In-Vitro Study. Journal of Functional Biomaterials, 14(4), 201. https://doi.org/10.3390/jfb14040201

